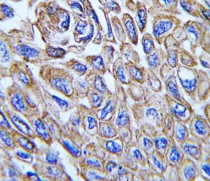

ARG55355
anti-ALDH3A1 antibody
anti-ALDH3A1 antibody for IHC-Formalin-fixed paraffin-embedded sections,Western blot and Human
Cell Biology and Cellular Response antibody; Metabolism antibody; Neuroscience antibody; Signaling Transduction antibody
Overview
| Product Description | Rabbit Polyclonal antibody recognizes ALDH3A1 |
|---|---|
| Tested Reactivity | Hu |
| Predict Reactivity | Ms, Bov |
| Tested Application | IHC-P, WB |
| Host | Rabbit |
| Clonality | Polyclonal |
| Isotype | IgG |
| Target Name | ALDH3A1 |
| Antigen Species | Human |
| Immunogen | KLH-conjugated synthetic peptide corresponding to aa. 254-284 (Center) of Human ALDH3A1. |
| Conjugation | Un-conjugated |
| Alternate Names | Aldehyde dehydrogenase, dimeric NADP-preferring; EC 1.2.1.5; ALDHIII; Aldehyde dehydrogenase family 3 member A1; Aldehyde dehydrogenase 3; ALDH3 |
Application Instructions
| Application Suggestion |
|
||||||
|---|---|---|---|---|---|---|---|
| Application Note | * The dilutions indicate recommended starting dilutions and the optimal dilutions or concentrations should be determined by the scientist. | ||||||
| Positive Control | A549 |
Properties
| Form | Liquid |
|---|---|
| Purification | This antibody is prepared by Saturated Ammonium Sulfate (SAS) precipitation followed by dialysis against PBS. |
| Buffer | PBS and 0.09% (W/V) Sodium azide |
| Preservative | 0.09% (W/V) Sodium azide |
| Storage Instruction | For continuous use, store undiluted antibody at 2-8°C for up to a week. For long-term storage, aliquot and store at -20°C or below. Storage in frost free freezers is not recommended. Avoid repeated freeze/thaw cycles. Suggest spin the vial prior to opening. The antibody solution should be gently mixed before use. |
| Note | For laboratory research only, not for drug, diagnostic or other use. |
Bioinformation
| Database Links |
Swiss-port # P30838 Human Aldehyde dehydrogenase, dimeric NADP-preferring |
|---|---|
| Gene Symbol | ALDH3A1 |
| Gene Full Name | aldehyde dehydrogenase 3 family, member A1 |
| Background | Aldehyde dehydrogenases oxidize various aldehydes to the corresponding acids. They are involved in the detoxification of alcohol-derived acetaldehyde and in the metabolism of corticosteroids, biogenic amines, neurotransmitters, and lipid peroxidation. The enzyme encoded by this gene forms a cytoplasmic homodimer that preferentially oxidizes aromatic and medium-chain (6 carbons or more) saturated and unsaturated aldehyde substrates. It is thought to promote resistance to UV and 4-hydroxy-2-nonenal-induced oxidative damage in the cornea. The gene is located within the Smith-Magenis syndrome region on chromosome 17. Multiple alternatively spliced variants, encoding the same protein, have been identified. [provided by RefSeq, Sep 2008] |
| Function | ALDHs play a major role in the detoxification of alcohol-derived acetaldehyde. They are involved in the metabolism of corticosteroids, biogenic amines, neurotransmitters, and lipid peroxidation. This protein preferentially oxidizes aromatic aldehyde substrates. It may play a role in the oxidation of toxic aldehydes. [UniProt] |
| Cellular Localization | Cytoplasm. |
| Research Area | Cell Biology and Cellular Response antibody; Metabolism antibody; Neuroscience antibody; Signaling Transduction antibody |
| Calculated MW | 50 kDa |
Images (2) Click the Picture to Zoom In